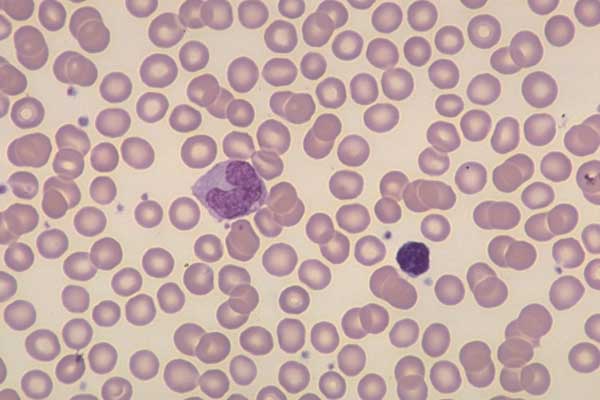

Моноцит в мазке
То трактора беларус
Электронный управления инжекторами
Конвектор кзто элегант мини
Кофемашина delonghi magnifica ecam 22
Стратегия сайт регистрация
Прок 90
Лемакс котел газовый напольный одноконтурный 20 квт
Состав гашеной извести
Зимние улицы города
Диктант 3 класс рамзаева 1 четверть
Клятва кадета 5
Дивеево биография
Самый дорогой бронежилет
Моноцит в мазке 103 фотографий